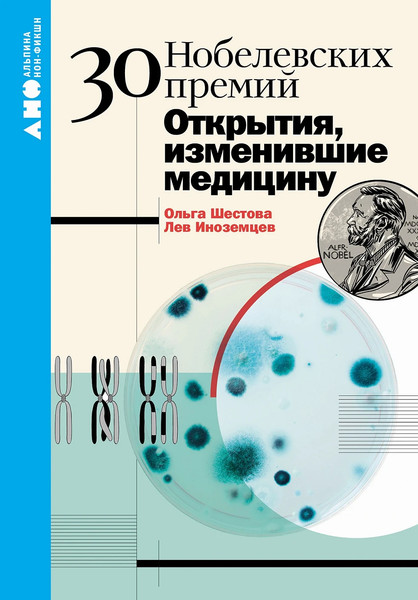
Изображение товара Книга Альпина 30 нобелевских премий, мягкая обложка (Шестова Ольга, Иноземцев Лев)

Книга Альпина 30 нобелевских премий, мягкая обложка (Шестова Ольга, Иноземцев Лев)



Категория
научно-популярная литература
Тематика
медицина
Автор
Шестова О.
Основные
- Тип
- книга
- ISBN
- 9785002231201
- Категория
- научно-популярная литература
- Тематика
- медицина
- Автор
- Шестова О.
- Издательство
- Альпина
- Серия
- Наука о здоровье
- Язык издания
- русский язык
- Формат издания
- уменьшенный (карманный)
- Размер издания
- 120×170 мм
- Обложка
- мягкая обложка
- Количество страниц
- 240
- Год издания
- 2024 г.
- Вес
- 161 г
Страна производства: Россия
Производитель: ООО «Альпина Диджитал», ул. 4-я Магистральная, д. 5, строение 1, г. Москва, РФ
Импортер в РБ: ООО "Триовист", 220020, г. Минск, ПОБЕДИТЕЛЕЙ пр., дом № 100, офис 203
Производители оставляют за собой право изменять внешний вид, характеристики и комплектацию товара, предварительно не уведомляя продавцов и потребителей. Просим вас отнестись с пониманием к данному факту и заранее приносим извинения за возможные неточности в описании и фотографиях товара. Будем благодарны вам за — это поможет сделать наш каталог еще точнее!